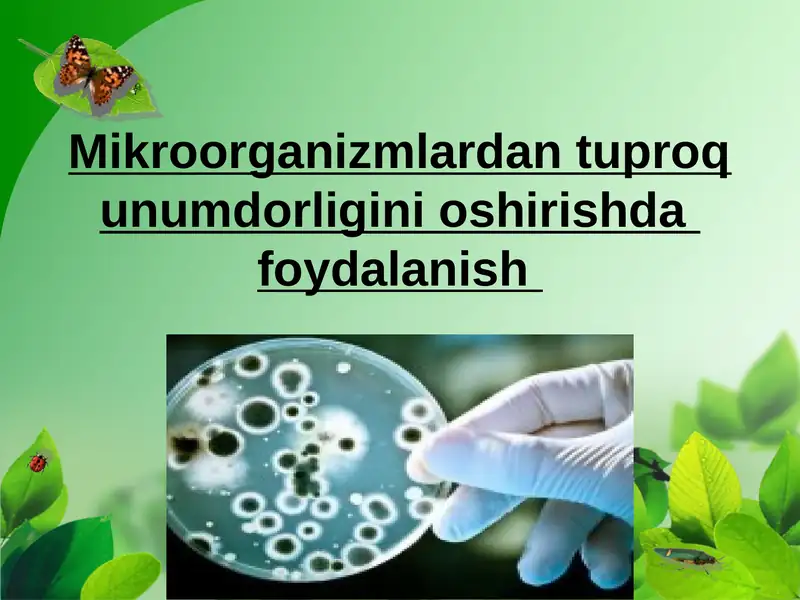
card img

Barchasi
TaqdimotlarKurs ishlariMustaqil ishlarDiplom ishlariBlankalarBiznes rejalarElektron kitoblarStatistikaMaqolaPlakatlarLoyihalarIjodiy IshlarAmaliy ishlarDasturlash tillariNamunaviy hujjatlarO'quv qo'llanmalarTarqatma materiallarDars ishlanmalarTestlarReferatlarIxtiro patentiDissertatsiya ishlariLabaratoriya Ishlari
.pptx

QISHLOQ XO‘JALIK EKINLARI URUG‘INING FIZIK-MEXANIK XOSSALARINIO‘RGANISH.
7 500 so’m
.pptx
Mikroorganizmlardan tuproq unumdorligini oshirishda foydalanish
5 000 so’m
.pptx

O‘simlik gullarining changlanish usullari Biotik va Abiotik changlanish
10 000 so’m
.pptx

Bakteriyalarning antibiotiklarga chidamli shakllarini paydo bo‘lish mexanizimlari.
5 000 so’m
.ppt

O'simliklar olami
5 000 so’m
.pptx

Gultojixo’rozdoshlar oilasi
5 600 so’m
.pptx

O'rta Osiyo olimlarining oʻsimliklar haqidagi fikrlari.Yuksak o'simliklarning taksonomik tarixi.
4 000 so’m
.pptx

O’simliklarni sho’rlanishga chidamliligi: 5 ta madaniy o’simlik misolida shaxsiy tajriba
8 500 so’m
.pptx

O‘simliklarda hosil bo‘ladigan immun tizimi, uning ta’siri va fiziologiyasi
7 500 so’m
.pptx

O’simliklarda hosil bo’ladigan immun tizimi: fiziologiyasi va ta’siri
8 900 so’m
.pptx

Stress reaksiyalari
7 400 so’m
.pptx

Oʻsimlik chidamliliga tuproq holatining taʼsiri
7 500 so’m
.pptx

O‘simliklarda stress reaksiyalari
6 900 so’m
.pptx

O‘simliklarda stress fiziologiyasi va ularning moslanish mexanizmlari
7 500 so’m
.pptx

Osimliklarda_umumiy_tizim_va_fiziologiyasi
6 500 so’m
.pptx

O'simlikning sho'rlanishga chidamliligi.
6 900 so’m
.pptx

O'simlik_chidamliligiga_agrotexnik_tadbirlarning_ta'siri
6 500 so’m
.pptx

O‘simlik chidamliligiga oziqlanish sharoitining ta’siri
6 900 so’m
.pptx

O‘simlik chidamliligiga tuproq holatining ta’siri
6 900 so’m
.pptx

stressning turli mexanizmlari
6 900 so’m
.pptx

O’QUV –TARBIYA JARAYONINI TAKOMILLASHTIRISHDA USLUBIY TA’MINOT ROLI
7 900 so’m
.pdf

Dorivor o’simliklarni suniy ko’paytirish va yetishtirish texnologiyasi
2 000 so’m
.pdf

DORIVOR O’SIMLIKLARNI TAYYORLASH VA SAQLASH
1 000 so’m
.pdf

Zamburug'lar
2 000 so’m
.pdf

Sariq-yashil, pirrofit, diatom va oltin-tusli suvo'tlar bo'limi
3 000 so’m
.pdf

Qo'ng'ir suvo'tlar-Phaeophyta
1 000 so’m
.pdf

Qizil suvo'tlar Rhodophyta
2 000 so’m
.pptx

To’pgullar, ularning asosiy morfologik belgilariga ko’ra tiplarga bo’linishi
3 000 so’m
.pptx

Zanjabil-Zingiber-officinale-Botanik-Xususiyatlari-va-Dorivorlik-Ahamiyati
1 000 so’m
.pptx

Dorivor-Osimlik-Mahsulotlarini-Anatomik-va-Mikroskopik-Tahlil-Usullari
1 000 so’m
.pdf

Qizilmiya-Glycyrrhiza-glabra-Umumiy-Tushuncha
2 000 so’m
.pptx

AYIQTOVONDOSHLAR OILASI
3 900 so’m
.pptx

Plants are our_life.pptx
5 000 so’m
.pptx

Bargning tuzilishi va tiplarini o’rganish
8 000 so’m
.pptx

Noyob landshaftlar va tabiiy yodgorliklarni holati muhofazasi
8 500 so’m
.pptx

O`simlik to`qimalari. Uning xillari va vazifalari
2 000 so’m
.pptx

КРАСНАЯ КНИГА РЕСПУБЛИКИ УЗБЕКИСТАН. THE RED DATA BOOK OF UZBEKISTAN
2 000 so’m
.pptx

loladoshlar oilasi slayd
6 000 so’m
.ppt

Baliqlarning ichki tuzilishi ” dars ishlanma
15 000 so’m
.pptx

Membranaga ega boʻlmagan organoidlar
10 000 so’m
.ppt

OROLLARDAGI, ICHKI SUV XAVZALARIDAGI VA DUNYO OKEANI ORGANIZMLARI HAMDA ULARNING BIOGEOGRAFIK XUSUSIYATLARI
9 000 so’m
.ppt

QURUQLIK ASOSIY BIOMLARINING ZONAL TARQALISHI VA BALANDLIK MINTAQALARI
9 000 so’m
.ppt

YER SHARINING QURUQLIK QISMINI FLORISTIK VA FAUNISTIK RAYONLARI
9 000 so’m
.ppt

ORGANIZMLAR VA ULARNING JAMOALARI TARQALISHINING GEOGRAFIK QONUNIYATLARI
14 000 so’m
.ppt

ORGANIZMLARNING EKOLOGIK GEOGRAFIYASI
15 000 so’m
.ppt

AREALLAR HAQIDA TUSHUNCHA
15 000 so’m
.ppt

Ekosistema. Biom va biogeotsenoz
15 000 so’m
.ppt

BIOTIK VA ANTROPOGEN OMILLAR
15 000 so’m
.ppt

ORGANIZMLARNING TARQALISH OMILLARI. ABIOTIK OMILLAR
15 000 so’m
.ppt

BIOSFERA, CHEGARALARI, BIOMASSA BIOLOGIK MAXSULDORLIK
15 000 so’m
Tayyor mahsulotlardan foydalanish qanday ishlaydi?

Qidiring va tanlang
Katalogdan yoki qidiruv orqali sizga kerakli tayyor mahsulotni toping.

Sotib oling
Xavfsiz to‘lov tizimi orqali mahsulotni sotib oling — narx va shartlar oldindan ko‘rinadi.

Yuklab oling va foydalaning
Mahsulotni darhol yuklab oling va ishlatishni boshlang.